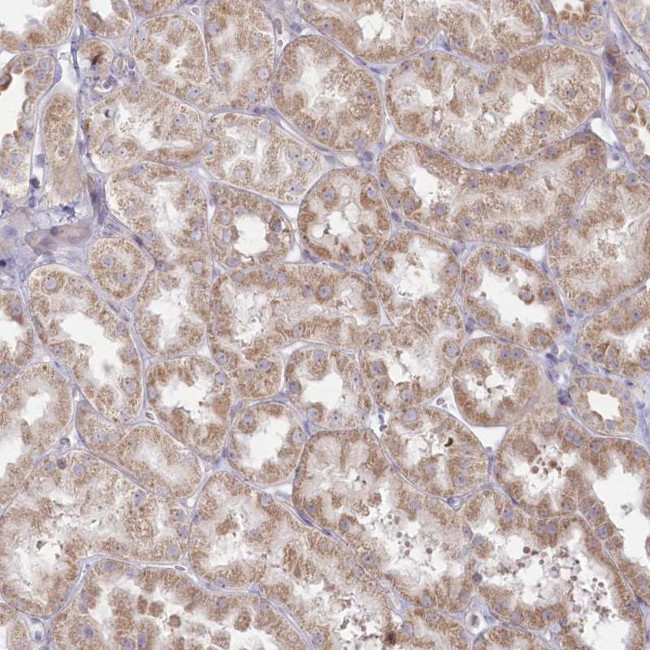
MTG1 Antibody in Immunohistochemistry (Paraffin) (IHC (P))

Search
Invitrogen
MTG1 Polyclonal Antibody
{{$productOrderCtrl.translations['antibody.pdp.commerceCard.promotion.promotions']}}
{{$productOrderCtrl.translations['antibody.pdp.commerceCard.promotion.viewpromo']}}
{{$productOrderCtrl.translations['antibody.pdp.commerceCard.promotion.promocode']}}: {{promo.promoCode}} {{promo.promoTitle}} {{promo.promoDescription}}. {{$productOrderCtrl.translations['antibody.pdp.commerceCard.promotion.learnmore']}}

Please note: We are reviewing Western blot images included in the antibody testing data in our catalog, including those provided by third parties. Unless expressly labeled or annotated as “raw-unedited”, Western blot images included in the antibody testing data in our catalog may have been edited, optimized or otherwise adjusted for presentation.
产品信息
PA5-58127
种属反应
宿主/亚型
分类
类型
抗原
偶联物
形式
浓度
规格
纯化类型
保存液
内含物
保存条件
运输条件
RRID
产品详细信息
Immunogen sequence: QHLRKGKATR VGGEPGITRA VMSKIQVSER PLMFLLDTPG VLAPRIESVE TGLKLALCGT VLDHLVGEET MADYLLYTLN KH
Highest antigen sequence identity to the following orthologs: Mouse - 91%, Rat - 91%.
靶标信息
Mitochondrial GTPase. May be involved in assembly of the large ribosomal subunit.
仅用于科研。不用于诊断过程。未经明确授权不得转售。
篇参考文献 (0)
生物信息学
蛋白别名: GTP-binding protein 7; Mitochondrial GTPase 1; Mitochondrial ribosome-associated GTPase 1; RP11-108K14.2
基因别名: GTPBP7; MTG1
Entrez Gene ID: (Human) 92170